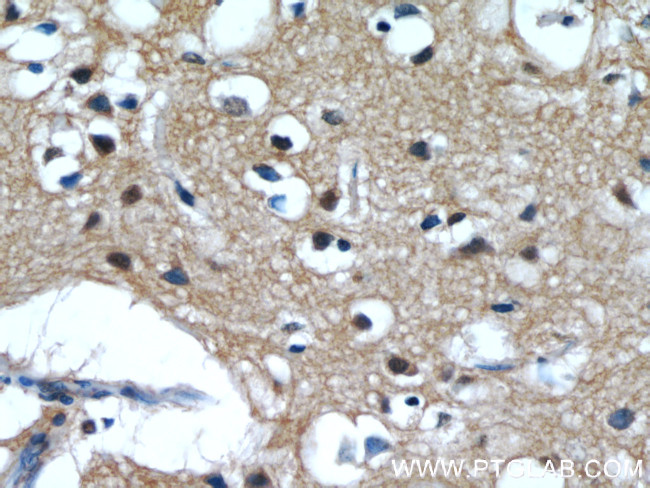
IMPDH2 Antibody in Immunohistochemistry (Paraffin) (IHC (P))

Search
Proteintech
IMPDH2 Polyclonal Antibody
{{$productOrderCtrl.translations['antibody.pdp.commerceCard.promotion.promotions']}}
{{$productOrderCtrl.translations['antibody.pdp.commerceCard.promotion.viewpromo']}}
{{$productOrderCtrl.translations['antibody.pdp.commerceCard.promotion.promocode']}}: {{promo.promoCode}} {{promo.promoTitle}} {{promo.promoDescription}}. {{$productOrderCtrl.translations['antibody.pdp.commerceCard.promotion.learnmore']}}
产品信息
55398-1-AP
宿主/亚型
分类
类型
抗原
偶联物
形式
浓度
保存条件
运输条件
产品详细信息
This antibody is specific to IMPDH2.
靶标信息
This gene encodes the rate-limiting enzyme in the de novo guanine nucleotide biosynthesis. It is thus involved in maintaining cellular guanine deoxy- and ribonucleotide pools needed for DNA and RNA synthesis. The encoded protein catalyzes the NAD-dependent oxidation of inosine-5'-monophosphate into xanthine-5'-monophosphate, which is then converted into guanosine-5'-monophosphate. This gene is up-regulated in some neoplasms, suggesting it may play a role in malignant transformation.
仅用于科研。不用于诊断过程。未经明确授权不得转售。